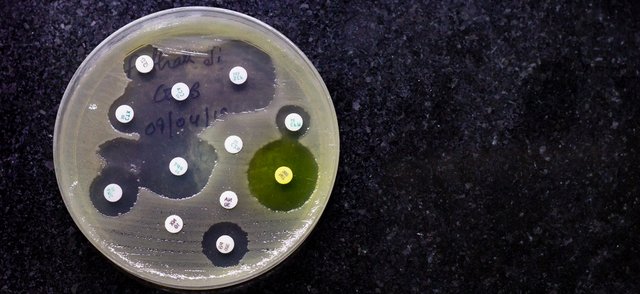
AMR AMR

Antibiotic Developments
BioVersys receives funding to develop new class of antibiotics to treat multidrug-resistant bacterial infections
Switzerland-based pharmaceutical company BioVersys has been awarded up to $4.35 million in funding to develop a new class of antibiotics for its work in developing a new class of antibiotics. Read more
7 Jun 2021
Current pipeline for antibiotics insufficient in tackling drug resistance
The current pipeline for antibiotics is insufficient in addressing drug resistance in the world’s most dangerous bacteria, a new report by the World Health Organisation has revealed. Read more
21 Apr 2021
Antibiotic Research UK launches £200K grants programme
Antibiotic Research UK (ANTRUK) has launched a small research grants programme worth up to £200,000, for researchers working on projects tackling antibiotic resistance. Read more
14 Apr 2021
Novo Holdings launches new funding round for AMR projects
The next proposal round of the Novo Holdings REPAIR Impact Fund is now open for life science companies developing new treatments to combat antimicrobial resistance (AMR). Read more
29 Mar 2021
New framework released for responsible use of antibiotic treatments
A framework has been released so that treatments targeting antibiotic-resistant bacteria are used responsibly and that the spread of antibiotic-resistant bacteria is minimised when new products are launched onto the market. Read more
23 Mar 2021
GSK to receive CARB-X funding to develop superbug vaccines
GSK is to receive $18 million in funding for the development of new vaccines that can prevent serious infections caused by two different pathogens. Read more
1 Mar 2021
AMR in Orthopedics – Benefits of topical treatment and latest advances
Michael Harris, chief executive officer of Biocomposites explores the threat of antibiotic resistance and how antibiotics are being used within the orthopaedics industry. Read more
7 Oct 2021
Improving our approach to fighting AMR
Oliver Schacht, CEO of precision medicine and genomics analysis company OpGen explores what we need to do to improve our fight against antimicrobial resistance (AMR). Read more
11 Aug 2021
The state of bioinformatics in the fight against AMR
Oliver Schacht, CEO of OpGen, Inc., examines the potential of bioinformatics in helping to fight antimicrobial resistance. Read more
27 Jan 2021
Sponsored Content
Pfizer CentreOne. Coating: Curing Your Complex Oral Solid Dose challenges
Access our recent webinar and discover how coatings expertise could transform your oral solid dose (OSD). Let's collaborate. Read more
18 May 2021
ACG rebrands with commitment to making world healthier
Pharmaceutical solutions provider ACG has rebranded to highlight its commitment to making the world healthier. Read more
4 Nov 2021
Pharma Manufacturing News + Latest Pharmaceutical Manufacturing News
New Information Standard aims to reduce medication errors in England
A new Information Standard has been published in England to help reduce medication errors and improve patient safety. Read more
1 Nov 2021
Pharma Manufacturing News + New Drug Development & Regulatory News
Over-70s experiencing drop in Covid antibodies
A drop in the levels of Covid antibodies found in 70–74-year-olds has been recorded, prompting calls for the UK government to step up its booster campaign and to introduce more widespread antibody testing. Read more
1 Nov 2021
Edinburgh researcher gains funding for immunotherapy research into cancer
An Edinburgh researcher working on new therapies for difficult-to-treat cancers has become one of the first recipients of $20m worth of funding from an industry and academia-led initiative. Read more
27 Oct 2021
Pharma Manufacturing News + Pharma Finance and Investment News
Eva Health Technologies launches charity initiative for Covax
A charity initiative in support of Covax has been launched by electronic health record company Eva Health Technologies. Read more
27 Oct 2021
GSK Consumer Healthcare unveils 3-year programme to support pharmacists
GSK Consumer Healthcare has unveiled a three-year programme to support pharmacists with better training, mental health provisions and ways to manage their workload. Read more
26 Oct 2021
Sponsored Content
Drive leads and engagement with a European Pharmaceutical Manufacturer Webinar
Webinars offer a multi-layered marketing outcome, enabling you to tell your story to a global audience, define your organisation as a thought leader and simultaneously deliver a healthy number of leads for your sales team to get to work on. Read more
25 May 2021
Sponsored
Sponsored Content
Pfizer CentreOne. Coating: Curing Your Complex Oral Solid Dose challenges
Access our recent webinar and discover how coatings expertise could transform your oral solid dose (OSD). Let's collaborate. Read more
18 May 2021
Sponsored Content
Drive leads and engagement with a European Pharmaceutical Manufacturer Webinar
Webinars offer a multi-layered marketing outcome, enabling you to tell your story to a global audience, define your organisation as a thought leader and simultaneously deliver a healthy number of leads for your sales team to get to work on. Read more
25 May 2021
ProClinical
ProClinical is a leading international recruitment company that assists life sciences organisations in combating unmet medical need by matching talented people with the jobs where they will make the most impact. Read more

_cb-94ac852920dc020a3cf24010da2da0b1-w-640.jpg)

_cb-32b3f5f29f984a1c9d32d3151f3ead30-w-640.png)

_cb-8da228345610c73f9f3ecb4e013f8d4b-w-640.png)




